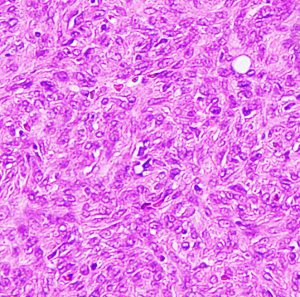

孤在線維性腫瘍 SFT solitary fibrous tumor/血管外皮腫 / hemangiopericytoma
ヘマンジオペリサイトーマ,血管外皮腫,血管周皮細胞腫,血管外皮細胞腫,血管周皮腫,孤在線維性腫瘍は全て同じものです
- 再発率が高い,全身転移するというのが大きな特徴です
- 脳外科医にはヘマンジオペリサイトーマという名称の方がわかりやすいです
- 胸膜の間葉系組織から発生する腫瘍ですが,体の中の軟部組織ならどこからでも発生します
- 脳腫瘍の0.4%くらいで珍しい腫瘍です
- 男性に少し頻度が高くて,髄膜腫より少し若い成人に発生します
- でも,小児にもできます
- 頭蓋内・脳では髄膜・硬膜に発生します
- だから髄膜腫 meningioma ととても似ています
- 頭蓋底では神経鞘腫 schwannomaと誤診されることもあります
- 髄膜の他には,脳軟膜下,脳室,脊髄神経根から発生することがあります
- 頭蓋内が8割で,脊椎管内が2割です
- 硬膜,脳組織,神経,頭蓋底骨に浸潤します
- 病理学的には,8割くらいが良性腫瘍で,2割くらいが悪性腫瘍です
- 頭蓋底あるいは頭蓋内に発生するものは悪性腫瘍の方が多いです
- グレード 1,グレード2,グレード3があります
- グレード1の良性はSFT solitary fibrous tumorだけです
- 組織診断でヘマンジオペリサイトーマと言われるのは,グレード2か3の悪性です
- 病理学的には良性でも,手術で取りきれない時に臨床的には悪性腫瘍といえます
- 治療は外科手術で完全摘出することで,完全摘出できれば治ります
- 取り残すと高率に再発(再燃)します
- 化学療法(制がん剤)は効きませんし,放射線治療にも抵抗性です
- 良性のSFT グレード 1であっても頭蓋内のものは,グレード2の非定型髄膜腫に近い臨床経過をたどります
- 手術で全摘出できなくて再燃をしても生命予後は短くはありません
- 腫瘍の大きくなる速度はさまざまでMIB-1染色率で予測します
- 手術で残った腫瘍が2−3ヶ月で大きくなってしまうことも,数年でゆっくり大きくなることもあります
- 悪性度の高いグレード3のSFT/ヘマンジオペリサイトーマは,肉腫としての性格を有します
- 悪性のSFTでは全摘出しても再発率は6割以上あります
- しかし,取り残した腫瘍あるいは悪性SFTには定位放射線治療(放射線外科治療)や陽子線治療 IMRT が用いられます
- 悪性のSFTは全身転移することが多いです
- 髄液に乗って脊髄に転移(播種)します
- こうなると抗がん剤も放射線治療もあまり有効ではありません
- グレードの高いSFTは,「悪性軟部腫瘍」とも病理診断できるので,分子標的薬パゾパニブ pazopanib (商品名 ヴォトリエント) を保険診療で使用することができます
静脈洞交会 confluence に浸潤しているものです。直静脈洞は閉塞しています。右のMRIでは,ガドリニウム増強像が強弱まばらになっています。髄膜腫と診断したいのですが,ちょっと何かが違うというのがSFTです。硬膜や骨や脳に浸潤性格を有します。亜全摘出して術後に54グレイの放射線治療をしました。

5年後に小脳内に再発しました。全摘出したのですが,その後もあちこちに再発を繰り返しています。最初はグレード2でしたが,再発を繰り返すと増大速度が速くなり,再発までの期間が短くなり,多発性再発となってきます。
画像所見
- 腫瘍自体は境界明瞭なmassとして描出されます
- 髄膜腫とのMRI画像所見の違いは,腫瘍がどこかで浸潤性で,形が不整形であること,腫瘍栄養動脈がsunburst所見を有しないことなどです
- MRI DWIやSWIでの鑑別は今ひとつ信頼性に欠けます
- ガドリニウムで均一に増強されることが多いのですが,不規則な増強所見が見られることがあります
- 周囲脳浮腫は高度であることが多く,脳実質内へも浸潤します
- 頭蓋骨の中に骨を壊しながらしみ込むように発育(浸潤)することがあります
- ですから,周囲の骨には肥厚ではなく破壊像を伴います
- 硬膜のどこにも発生しますが,後頭部の静脈洞近辺の頻度が高く脊髄硬膜は10%弱です
- 髄膜腫に反して,画像上も病理像でも石灰化をみることはほとんどありません
手術摘出は
- 血管が多く入っているので,手術の時には出血が多い腫瘍です
- 髄膜腫より硬膜や脳や神経組織や頭蓋軟部組織に癒着して浸潤します
- ですから,全摘出しようとすると脳神経組織の損傷が生じやすいです
- しかし,全摘出できないと再燃します
- SFT/ヘマンジオペリサイトーマ は,悪性度のある髄膜腫(グレード2非定型髄膜腫)と同様な手術方針のほうがいいです
- 術前に良性髄膜腫だと思って,無理しない手術で少し取り残した時,病理でSFTの診断が出れば,残っている腫瘍をまた開頭手術で根こそぎ摘出します
- 多少の無理をしても全摘出をめざしますが,神経組織損傷が大きくなると予想された場合には腫瘍を残して,手術後に定位放射線治療を行うという方針です
- しかし,SFTは放射線治療にも抵抗性ですから,高線量の定位放射線治療が必要で,SRTよりもSRS(放射線外科)を用います
- 緩和ではなくて治癒をめざすためにはこのような手術対応が必要です
放射線治療
- かなり強い高線量の放射線治療しか効きません
- ですから,周囲の正常組織,脳の被曝も大きくなります
- 方法としては,放射線外科治療 SRT,定位分割放射線治療 SRT, 頭蓋底では陽子線治療 proton beam などを選択します
化学療法
- 分子標的薬 パゾパニブはマルチチロシンキナーゼ阻害薬で,血管新生を阻害して腫瘍の増殖を抑えます
- 高悪性度SFTは血管構造を模倣して増殖する血管性腫瘍だから有効と考えられています
- ヴォトリエント錠 800mgの錠剤を空腹時に毎日服用します
- 効果がないと判断される時まで飲み続けるものです
- 5割ほどの患者さんで腫瘍が一時的に小さくなるという効果が期待されますが,はっきりした臨床研究はまだ途上にあり不明です
- また効果の持続時間も判明していません
- 下痢,倦怠感,高血圧と好中球減少が主たる有害事象です
画像と病理所見1
右中頭蓋窩から側頭下窩に抜けた,三叉神経鞘腫と誤診しやすいSFTです。dense collagen fiber の中に,核内空胞を有する異型細胞が密に増殖しています。MIB-1染色が10%程度と高いSFTでGrade IIb SFTと分類されるものです。
画像と病理所見2

この例は,膠原線維 collagenous tissueのなかに紡錘形の核を有する細胞 spindle cell が見られます。核の大小不同は見られますが,上の例よりはグレードが低いと捉えられます。しかし,この例のように一見グレードが低いと思われる例でも髄液播種や全身転移を生じることがあります。
画像と病理所見3
40代女性の後頭部傍矢状洞部の硬膜に発生したグレード3です。腫瘍周囲の強い浮腫のために,頭頂葉のゲルストマン症候で発症しました。術前診断は髄膜腫でしたが,腫瘍内部にのう胞(液体が溜まっている)があり,髄膜腫としては典型的な画像ではありません。右側の血管撮影にみられるように,上矢状洞が一部狭窄して腫瘍が浸潤している所見があり,腫瘍が濃染します。腫瘍の周囲の脳には出血がありました。大脳鎌と上矢状洞の壁を含めて全摘出しました。
画像と病理所見4

40代男性の大脳鎌テント接合部の硬膜に発生したグレード3です。激しい出血のために腫瘍摘出を部分摘出で中断せざるを得なかった例です。
この例でも,硬膜発生腫瘍ということは手術前の画像診断で解ってはいたのですが,髄膜腫と異なり不整な形をしてのう胞があり,一部は腫瘍壊死でした。
上の2例は,髄膜腫とは違うと一見してわかる,典型的なSFT/ヘマンジオペリサイトーマの例ですが,髄膜腫と鑑別できないようなものの方が多いです。
画像と病理所見5
この例は再発を繰り返したグレード3のものです。密な異型細胞の増殖があるだけでもはや特徴的な構造を示しません。免疫染色でSTAT6 nuclear expressionとして検出され,核内STAT6が陽性でSFTと診断されます。MIB-1は20%を超えています。再発を繰り返すとこのような病理像になって来ます。
画像と病理所見6
60代女性に偶然発見されたもので,小さな髄膜腫のようにみえ経過観察されました。5年間の経過で徐々に増大しました。

硬膜から発生してと頭蓋骨内に浸潤して骨破壊を伴いながら増殖する腫瘍でした。周囲の硬膜と頭蓋骨削除をして全摘出できました。グレード2のSFTです。このようなものは感全摘出で完治します。
生存割合
Soyuer S, et al.: Intracranial hemangiopericytoma: the role of radiotherapy: report of 29 cases and review of the literature. Cancer 100: 1491-1497, 2004
この29例の報告では,10年生存割合は68%,しかし16例が頭蓋外転移しています。gross total resectionでは5年局所制御率は 84%,subtotal resectinでは38%であった。また,術後補助療法としての放射線治療の効果は有意なものとはいえないそうです。しかし結論として,局所再発と遠隔転移の多さから,とにかくgross total resectionを目指すことと局所放射線治療を加えることを勧めています。
放射線治療によって誘発される2次癌としての ヘマンジオペリサイトーマ
1984年 19歳の時に,松果体のジャーミノーマに全脳照射45グレイで治療されました(左CT)。1997年左蝶形骨縁にヘマンジオペリサイトーマが発生しました(中央と右のMRI)。手術で全摘出しましたが4年後,2001年に脊髄に播種再発してつらい経過を辿りました。眼窩壁を破る典型的なヘマンジオペリサイトーマの像で,放射線誘発髄膜腫との鑑別がとても大切なものです。
以下はちょっと専門的知識
- 病理診断では,Spindle cells are disposed in fascicles between prominent, eosinophilic bands of collagen.と表現されます
- 単調な組織構造を示し,patternless patternとも表現されます
- 膠原線維が多く細胞密度が低いものは本当の良性のグレード1です
- HE染色では,fibromaやmyxomaと鑑別ができないことがあります
- グレード2以上では髄膜腫より高い細胞密度と特有の血管構築 (staghorn vasculature, slit-like vascular channels)がみられます
- 免疫染色では,vimentin, CD34, Bcl2, CD99が強陽性,EMA, S-100, anti-cytokeratinが陰性となります
- 12q13にinversionがあり,NAB2とSTAT6遺伝子の融合があるために,免疫染色で細胞核にSTAT6の発現がみられます
- myxoid variantとcellular variantがあります
- 髄膜腫と同様にMIB-1染色率や壊死巣と予後に強い相関があります
- MIB-1の平均的な値は10%程度に達し,増殖速度が早く全摘後の再発までの期間も髄膜腫よりかなり短いといえます
- 壊死像はgrade IIIの特徴です
- 脱分化像 dedifferentiationを示すものは治療抵抗性で予後不良です
- gradingは以下のようにされますが,必ずしも明らかな線引きはありません
Grade I : 細胞密度が低く,核分裂像が少なく,膠原線維が多い
Grade I that corresponds most often to the highly collagenous, relatively low cellularity, spindle cell lesion previously diagnosed as solitary fibrous tumor;
Grade II : 高細胞密度が認められる
Grade II corresponds typically to the more cellular, less collagenous tumor with plump cells and “staghorn” vasculature that was previously diagnosed in the CNS as hemangiopericytoma.
Grade III : 核分裂像が10視野5個以上あり,高細胞密度
Grade III most often corresponds to what was termed anaplastic hemangiopericytoma in the past, diagnosed on the basis of 5 or more mitoses per 10 high-power fields.
左側の画像は照射後再発を手術摘出後です,数ヶ月で再燃しています,かなり早い増殖速度で再発してきて取りきれません
 文献情報
文献情報
SFTに対するパゾパニブの効果,第2相試験
Pazopanib for treatment of typical solitary fibrous tumours: a multicentre, single-arm, phase 2 trial. Lancet Oncol 2020
pazopanib抵抗性であることが分かっているmalignant-dedifferentiation typeを除く,転移性あるいは摘出不能な典型的なSFTに対して試験が行われました。31人中18人 (58%) でPR 部分奏功 PRがえられ,12人(39%) では SD 不変,,1人で進行悪化しました (Choi criteria)。
高悪性度 SFTに対するパゾパニブの第2相試験
Pazopanib for treatment of advanced malignant and dedifferentiated solitary fibrous tumour: a multicentre, single-arm, phase 2 trial. Lancet Oncol. 2019
進行性であり転移があるか摘出不能な悪性もしくは脱分化型 SFTで,ECOG PS 0-2の35人の患者さんにパゾパニブが投与されました。Choi criteriaでの評価では,18 人で(51%) でPR 腫瘍が小さくなり,9人(26%) ではSD 同じ状態, 8人 (23%) でPD 悪化しました。脱分化型 dedefferentiated SFTは有効性がないために途中で試験から外されました。半数ほどで,進行がある程度の期間抑えられるのであろうというくらいの結果です。残念ながら,治る治癒というのは期待はできません。
パゾパニブの効果
Lee SJ, et al.: Successful use of pazopanib for treatment of refractory metastatic hemangiopericytoma. Clin Sarcoma Res 4:13, 2014
全身転移したヘマンジオペリサイトーマにパゾパニブという制がん剤が有効であったとの報告です。転移してしまった3人の患者さんに使用され,腫瘍が小さくなったあるいは増大しないで数ヶ月経過しているとの報告です。治ったという結果ではありませんし,この薬剤で治るということは期待できません。pazopanibは,経口投与できるマルチキナーゼ阻害剤で,抗血管新生作用を持つので,腫瘍増大とか進行を抑制できる薬剤です。米国では進行悪性軟部腫瘍を対象として希少疾病用医薬品の指定を得ていますが,日本では2015年時点で認可されていません。
solitary fibrous tumorとhemangiopericyotomaの比較
Panel N, et al.: Solitary Fibrous Tumors and So-Called Hemangiopericytoma. Review Article, Sarcoma 2012, 2012
本来は孤在線維性腫瘍という呼称するべきで,ヘマンジオペリサイトーマというのは髄膜発生の孤在線維性腫瘍に限られて使用されると書かれています。
放射線外科治療
Sheehan J, et al.: Radiosurgery for treatment of recurrent intracranial hemangiopericytomas. Neurosurgery 51: 905-910, 2002
14例の再発hemangiopericytomaに平均線量で15Gyの放射線外科治療がされました。観察期間中央値21ヶ月で,11例(79%)で局所制御が可能でした。 80%で明らかな腫瘍縮小が認められ,29%(14例中の4例)で遠隔転移が生じているので,局所放射線外科治療は転移抑制には明らかな効果はないかもしれません。
文献
- Bisceglia M, et al.: Solitary fibrous tumor of the central nervous system: report of an additional 5 cases with comprehensive literature review. Int J Surg Pathol 19:476-486, 2011
- Bisceglia M, et al.: Solitary fibrous tumor of the central nervous system: a 15-year literature survey of 220 cases (August 1996-July 2011). Adv Anat Pathol 18:356-392, 2011
- Bouvier C, et al.: Solitary fibrous tumors and hemangiopericytomas of the meninges: overlapping pathological features and common prognostic factors suggest the same spectrum of tumors. Brain Pathol 22: 511-521, 2012
- Fargen KM, et al.: The central nervous system solitary fibrous tumor: a review of clinical, imaging and pathologic findings among all reported cases from 1996 to 2010. Clin Neurol Neurosurg. 113:703-710, 2011
- Pazopanib for treatment of typical solitary fibrous tumours: a multicentre, single-arm, phase 2 trial. Lancet Oncol 2020
- Lee SJ, et al.: Successful use of pazopanib for treatment of refractory metastatic hemangiopericytoma. Clin Sarcoma Res 4:13, 2014
- Mekni A, et al.: Solitary fibrous tumour of the central nervous system: pathological study of eight cases and review of the literature. Pathology. 41:649-654, 2009
- Panel N, et al.: Solitary Fibrous Tumors and So-Called Hemangiopericytoma. Review Article, Sarcoma 2012, 2012
- Sheehan J, et al.: Radiosurgery for treatment of recurrent intracranial hemangiopericytomas. Neurosurgery 51: 905-910, 2002

















